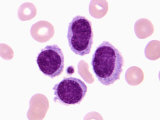

MOHSEN AZAD
قـــــــــــــــــارچ شناســـــــــــــــــــــی پزشکــــــــــــــــــــی
جدیدترین مطالب
لینک های وب
آرشیو وبلاگ
درباره وب

ســــــــــــــــــــــــــــــــــــــــــــــــــــلامی
به گــــــــــــرمی نـــــــــــــفسهاتون..
محسن
فوق لیسانس مدیکال مایکولوژی
و ســـــــــــــاکن شهر تهـــــــــــــــــران
هـــــــــــــــــــــــــــــــــــــــــــــستم.
امیــــــــــــــــــــــــــــــــــــدوارم که
لحظـــــــــــــــــات خـــــــــوب و خوشی
را در وبـــــــلاگم سپـــــــــــــــری نمایید.
.
.
1388 دانشگاه علوم پزشکی قم - کارشناسی
1393 دانشگاه علوم پزشکی اصفهان - کارشناسی ارشد
........(_\.........
.../_)...) \........
../ (....(__)......
.(__)...oooO....
Oooo..............
.
گفتم غم تو دارم گفتا غمت سر آید گفتم که ماه من شو گفتا اگر برآید
گفتم ز مهرورزان رسم وفا بیاموز گفتا ز خوب رویان این کار کمتر آید
گفتم که بر خیالت راه نظر ببندم گفتا که شبرو است او، از راه دیگر آید
گفتم که بوی زلفت گمراه عالمم کرد گفتا اگر بدانی هم اوت رهبر آید
گفتم خوشا هوایی کز باد صبح خیزد گفتا خنک نسیمی کز کوی دلبر آید
گفتم که نوش لعلت ما را به آرزو کشت گفتا تو بندگی کن کو بنده پرور آید
گفتم دل رحیمت کی عزم صلح دارد گفتا مگوی با کس تا وقت آن درآید
گفتم زمان عشرت دیدی که چون سر آمد گفتا خموش حافظ کاین غصه هم سر آید
جستجوی وب
موضوعات وب
لینک های مفید
پيوندهای روزانه
لینک های مفید
امکانات وب